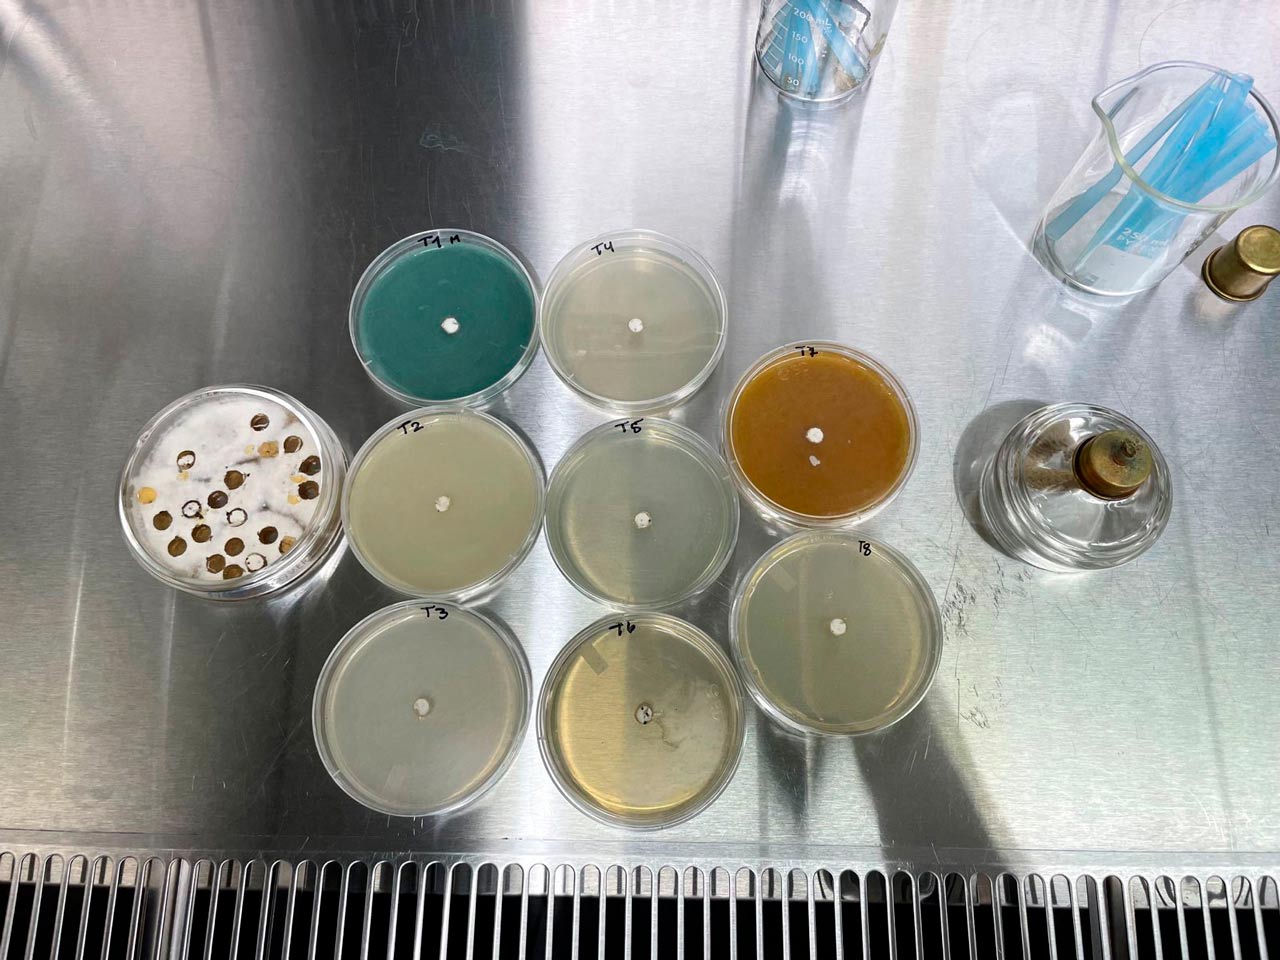

Completa el Formulario y envía tu muestra para diagnóstico fitosanitario

Últimas noticias

Completa el Formulario para reportar una plaga

Objetivos del programa
Generar conocimiento sobre las principales plagas y enfermedades que afectan los cultivos y poner a disposición de los sectores productivos las tecnologías que les permitan obtener una mayor producción y una mejor calidad de los productos.

Objetivos Específicos
- Generar y validar tecnología para el manejo integrado de plagas y enfermedades de granos básicos, hortalizas y frutales.
- Contribuir a generar información sobre plagas y enfermedades para entender sus mecanismos y población.


Consulta el mapa y mantente informado sobre la presencia de plagas en tu región.
Investigaciones realizadas
- Mancha Angular (P. griseola Sacc)
- Roya (U.appendiculatus)
- Antracnosis (C. Lindemuthianum)
- Trips de las flores del frijol(Megalurothrips usitatus)
- Evaluación de la susceptibilidad(Megalurothrips usitatus)
Mancha Angular
Nombre científico: Pseudocercospora grisceola Sacc
Los períodos alternos de lluvia y calor potencian el desarrollo de la enfermedad, las vainas infectadas presentan semillas mal desarrolladas o arrugadas. Los restos de cosecha o semilla contaminada son fuentes de inóculo, afecta hojas primarias, tallos, vainas y granos.
Síntomas: Se puede observar lesiones grises o pardas con márgenes definidos en forma angular delimitada en la nervadura principal como secundaria. En las vainas se observan manchas ovales o circulares con centros rojizos, en ocasiones con bordes de color más oscuro.
Trabajos realizados:
- Caracterización de razas de Mancha Angular (Pseudocercospora grisceola Sacc) del Frijol Común en el Altiplano Occidental de Guatemala



Evaluación de la susceptibilidad
Nombre científico: Megalurothrips usitatus
En Guatemala en el 2021 se confirmó la presencia del trips del frijol de dos bandas (Megalurothrips usitatus) (Racancoj et al., 2022) (Figura 1). Debido al daño que genera en el frijol común, como respuesta los agricultores están realizando aplicaciones de Piretroides (grupo 3) y Neonicotinoides (grupo 4). Sin embargo, ante la constante exposición a estas moléculas, los trípidos pueden generar resistencia (Cleveland et al., 2023).
Síntomas: El objetivo de la investigación fue evaluar la susceptibilidad de dos poblaciones de M. usitatus a la exposición de nueve insecticidas que pertenecen a los Neonicotinoides y Piretroides.


Roya
Nombre científico: Uromyces appendiculatus
El principal medio de dispersión del hongo es a través del viento. El hongo sobrevive en residuos de cosecha. Las condiciones ideales oscilan entre 17 a 27°C con una humedad relativa de 95%.
Síntomas: Se puede observar lesiones amarillas en las que se forma un punto con aspecto polvoso de color ladrillo o café los cuales van apareciendo en toda la hoja y planta. Cuando hay una infección severa puede haber hasta 100% de pérdidas.
Trabajos realizados:
- Caracterización de razas de roya (Uromyces appendiculatus) y antracnosis (Colletotrichum lindemuthianum) del frijol en el Altiplano Occidental


Antracnosis
Nombre científico: Colletotrichum lindemuthianum
Puede causar pérdidas hasta del 100% en el rendimiento cuando la enfermedad aparece temprano y cuando se siembra la semilla contaminada y las condiciones favorables se mantienen durante todo el ciclo del cultivo.
Síntomas: Los síntomas aparecen en el envés de las hojas, localizados a lo largo de las nervaduras de la hoja con lesiones de color rojo ladrillo a negro. También puede aparecer en los tallos en el caso de las vainas se producen lesiones redondas, hundidas donde se pueden observar pequeños puntos rosados. Estas lesiones también pueden aparecer en los pecíolos, las ramas, los tallos, los cotiledones y en las vainas. En vainas se producen lesiones redondas, hundidas, con borde bien definido, y centro oscuro donde se puede observar pequeños puntos de color rosado.
Trabajos realizados:
- Caracterización de razas de roya (Uromyces appendiculatus) y antracnosis (Colletotrichum lindemuthianum) del frijol en el Altiplano Occidental


Trips de la flor del frijol
Nombre científico: Megalurothrips usitatus
Causa daños en las flores y las vainas generando pérdidas en la producción. Debido al tipo de aparato bucal que posee generar un raspado en las vainas, causando grietas en la epidermis de las vainas. El aborto prematuro de las flores disminuye el rendimiento del cultivo.
¿Cómo se identifica?
- Megalurtotrips usitatus es un trips específico de leguminosas
- Se encuentra principalmente en las flores.
- Las ninfas son de color naranja y se distribuyen tanto en foliolos como en flores.
- Los adultos son de color café oscuro
- El daño de las vainas se reconoce como grietas y cicatrices marrón o bronceado
Trabajos realizados:
- Diagnóstico del comportamiento poblacional de Megalurothrips usitatus en el cultivo de frijol, y generación de tecnología para su manejo










Trips de la flor del frijol
Nombre científico: Megalurothrips usitatus
Causa daños en las flores y las vainas generando pérdidas en la producción. Debido al tipo de aparato bucal que posee generar un raspado en las vainas, causando grietas en la epidermis de las vainas. El aborto prematuro de las flores disminuye el rendimiento del cultivo.
¿Cómo se identifica?
- Megalurtotrips usitatus es un trips específico de leguminosas
- Se encuentra principalmente en las flores.
- Las ninfas son de color naranja y se distribuyen tanto en foliolos como en flores.
- Los adultos son de color café oscuro
- El daño de las vainas se reconoce como grietas y cicatrices marrón o bronceado
Trabajos realizados:
- Diagnóstico del comportamiento poblacional de Megalurothrips usitatus en el cultivo de frijol, y generación de tecnología para su manejo

Ver documento PDF









- Ácaro(Oligonychus pratensis)
- Chicharrita(Dalbulus maidis)
Ácaro del pasto
Nombre científico: Oligonychus pratensis
Se presenta principalmente en épocas secas y calurosas. Este ácaro se encuentra en el envés de las hojas de maíz, formando colonias densas que se alimentan del contenido celular, debilitando a la planta. La infestación suele iniciar en bordes de parcelas y avanzar hacia el interior del cultivo.
Síntomas: Hojas con punteado clorótico o decoloración amarilla a rojiza, pérdida de vigor y enrollamiento. En infestaciones severas, puede ocasionar marchitez o incluso la muerte de las hojas afectadas.














Chicharrita del maíz
Nombre científico: Dalbulus maidis
Los ambientes cálidos favorecen la proliferación de esta plaga, que actúa como vector de varias enfermedades importantes del maíz, como el achaparramiento y la ristra. Se desplaza fácilmente entre plantas, facilitando la propagación de fitopatógenos. Su presencia es más notoria en campos con alta densidad de siembra y escasa rotación de cultivos.
Síntomas: Las plantas afectadas presentan entrenudos cortos, clorosis generalizada, deformaciones en las hojas y espigas poco desarrolladas o sin grano. También se puede observar presencia de excreciones melosas y adultos saltadores al mover las plantas.


- Tizón tardío(Phytophthora infestans)
Tizón tardío
Nombre científico: Phytophthora infestans
Es un Chromista fungoide de la clase Oomicetes parásito de las plantas que produce una enfermedad conocida como tizón tardío o mildiu (o roya) de la papa. En época lluviosa puede llegar a causar el 100% de pérdidas en el cultivo.
Síntomas: en las hojas se puede apreciar manchas de color marrón claro u oscuro, se presentan en los bordes y puntas. En condiciones con humedad se forman vellosidades blanquecinas en el envés de la hoja. Las lesiones se expanden rápido, causando una necrosis y muerte del tejido. En los tallos y peciolos también se observan lesiones necróticas de color marrón, cuando está avanzada la enfermedad se quiebran fácilmente. En los tubérculos se presentan áreas ligeramente hundidas, al hacer un corte transversal se pueden observar estrías necróticas delgadas de color marrón.




- Podredumbre de raíces y corona(Neopestalotiopsis clavispora)
Podredumbre de raíces y corona
Nombre científico: Neopestalotiopsis clavispora
Es el agente causal de la podredumbre de raíces y corona en frutilla o fresa, una enfermedad emergente, que causa daños severos a este cultivo.
Síntomas: Se manifiesta necrosis en los bordes de las hojas y amarillamiento clorosis internerval. En casos avanzados la planta muere. Al hacer un corte en la corona de la fresa se observa un halo necrótico de color marrón. Las plantas establecidas en campo tienen un desarrollo lento y enraizamiento pobre.


- Tizón del arroz(Pyricularia oryzae/Pyricularia urashimae/Magnaporthe oryzae)
Tizón del arroz
Nombre científico: Pyricularia oryzae / Pyricularia urashimae / Magnaporthe oryzae
El tizón del arroz es una enfermedad causada por Pyricularia oryzae que afecta principalmente la maduración del grano de arroz, causando un bajo rendimiento. La etapa sexual de M. oryzae, se describe con el nombre de P. oryzae, (antes llamada P. grisae), clasificada en la familia Magnaporthaceae, de la división Ascomicete. (Chung y Han, 2020).
Síntomas: La enfermedad comienza con pequeñas manchas puntiformes verde grisáceas o azuladas. Al crecer se vuelven elípticas con un color típicamente grisáceo ceniciento en el centro, indicador de la esporulación del hongo y con bordes necrosados de color marrón rojizo. Los momentos en que la planta de arroz es más susceptible, son el estado de plántula y durante la floración.


Programa de Protección Vegetal
Dentro del que hacer del Programa de Protección vegetal está:

Generar y validar tecnologías
Para el manejo integrado de plagas en diversos cultivos.

Estudiar
Para el manejo integrado de plagas en diversos cultivos.

Determinar la virulencia
De razas patogénicas caracterizadas para diferentes cultivos.

Generar información
Sobre los posibles genes que confieren resistencia a las distintas razas caracterizadas de patógenos.

Realizar diagnósticos fitosanitarios y entomológicos
Diagnosticar la presencia de hongos, bacterias, virus, artrópodos y ácaros a través de distintas técnicas de diagnóstico.

Estudiar la dinámica poblacional
De las principales plagas y determinar los cambios de las mismas a través del tiempo.
Equipo de Investigadores
MSc. Inga. Agr. Luz de María Montejo
Coordinadora
Inga. Agr. Glenda Pérez
Investigadora
Inga. Agr. Astrid Racancoj
Investigadora